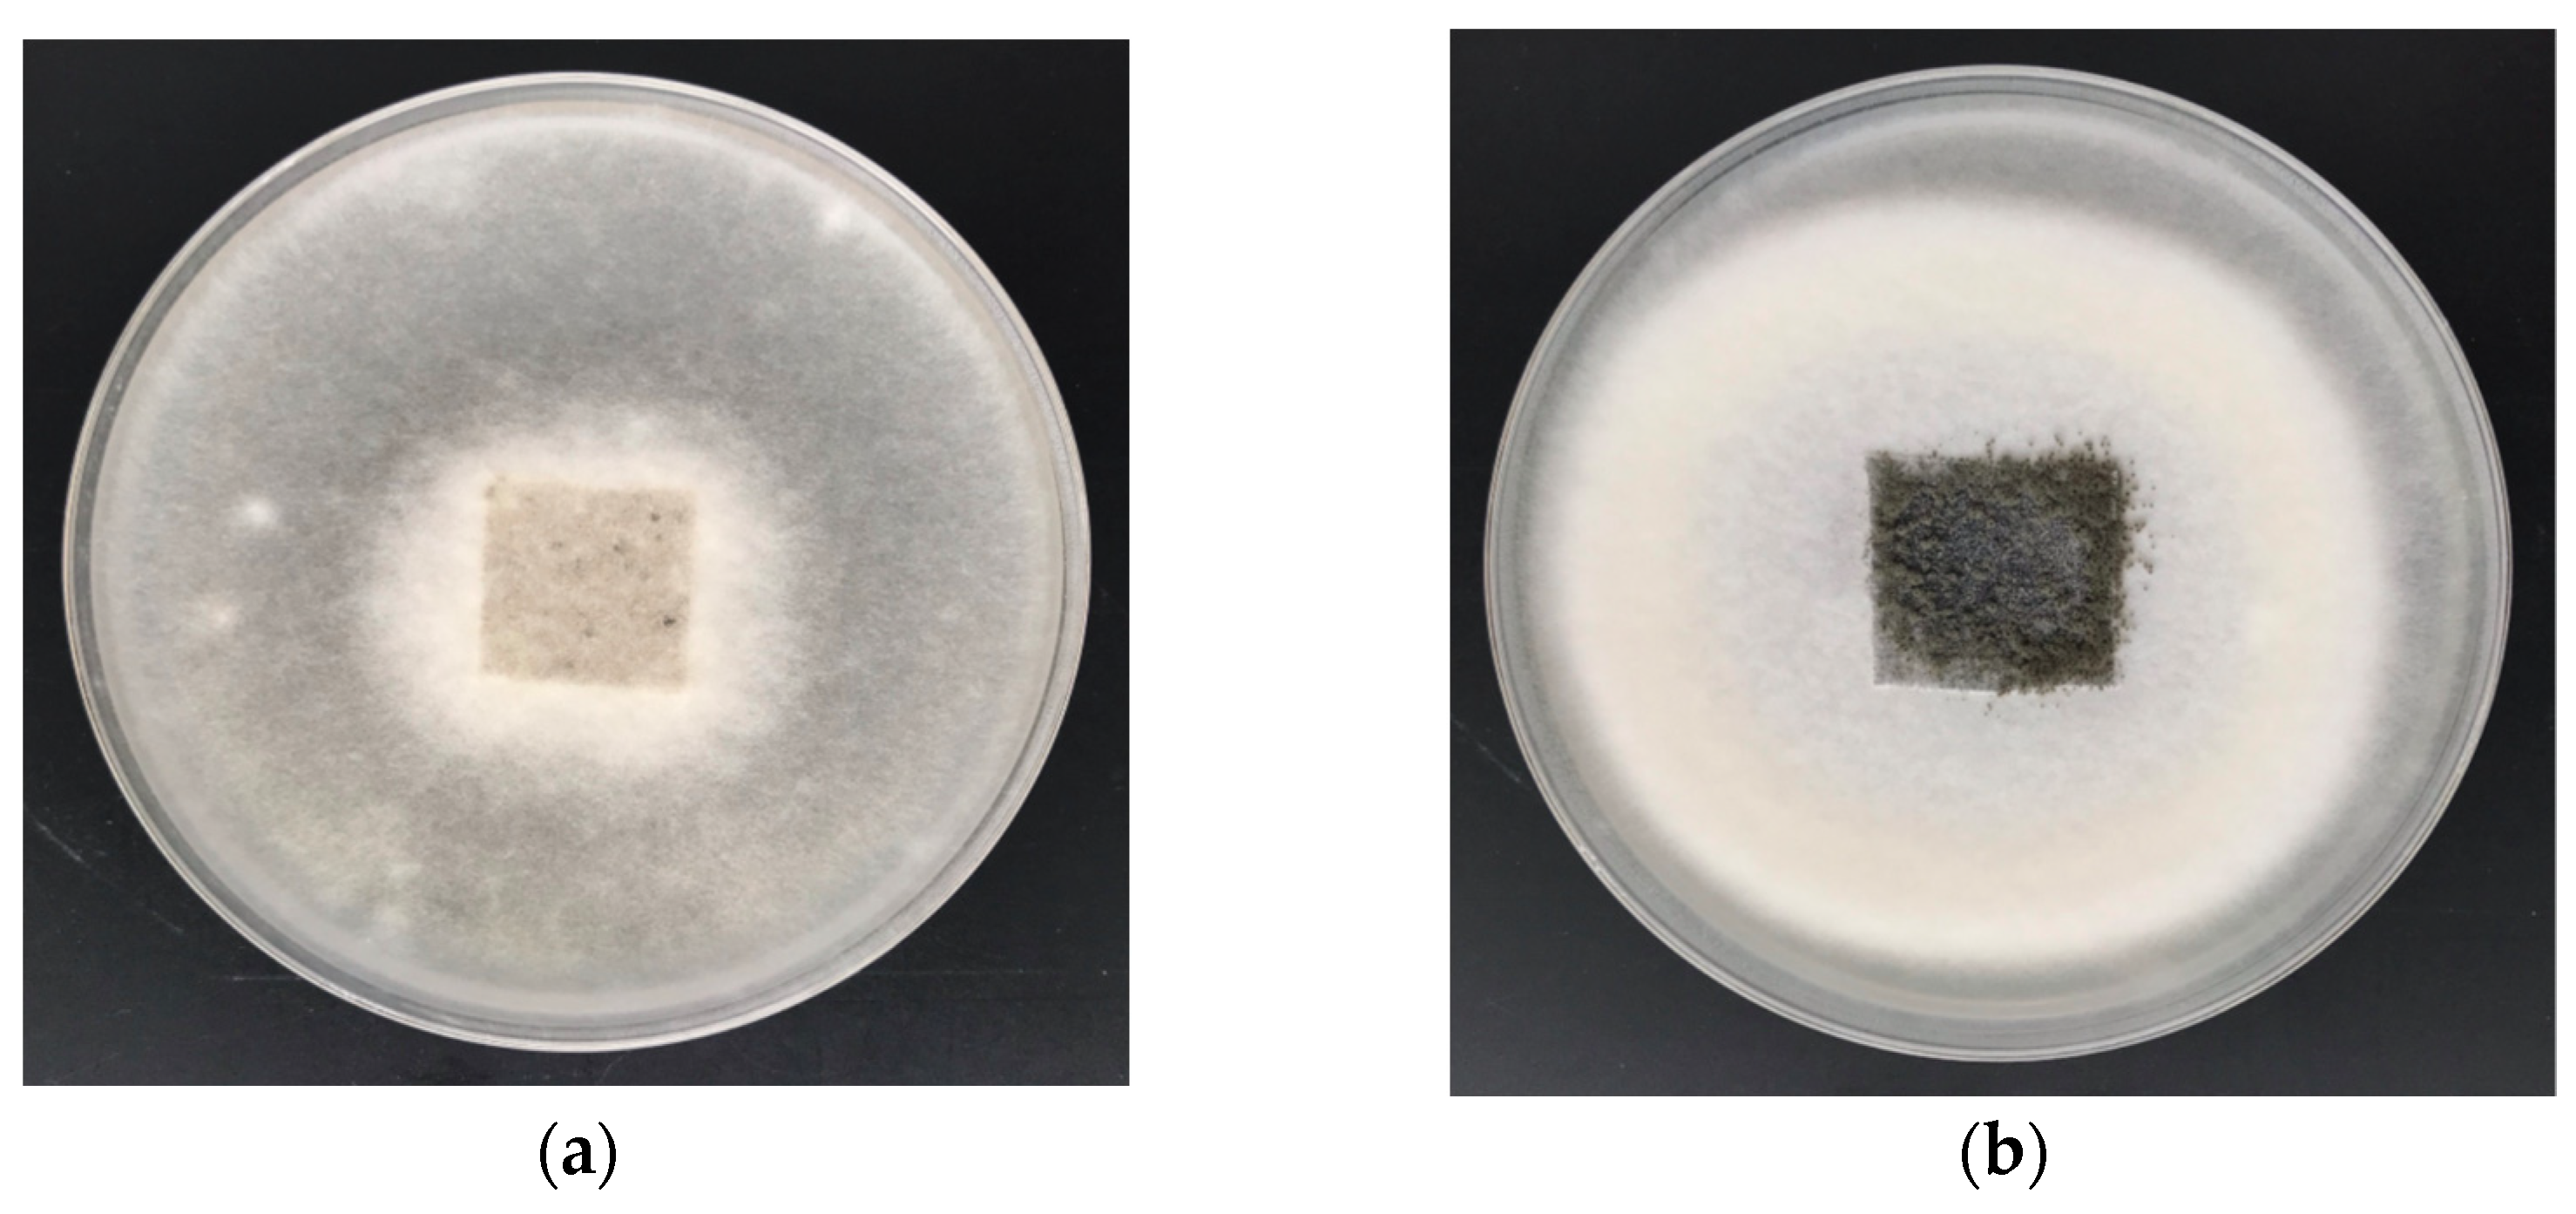
Materials 15 02746 g008

Preparation of Cotton–Zinc Composites by Magnetron Sputtering Metallization and Evaluation of their Antimicrobial Properties and Cytotoxicity
Abstract
:1. Introduction
2. Materials and Methods
2.1. Materials
2.1.1. Composite Components
- Medical fabric with a plain weave; qualitative composition: cotton (100% w/w); weight: 200 g/m2 (Andropol S.A., Andrychów, Poland);
- Zinc sputtering target with 99.9% purity with a rectangular size (798 × 122 × 6 mm) (Testbourne Ltd., Basingstoke, UK).
2.1.2. Bacterial and Fungal Strains
- Escherichia coli (ATCC 25,922, Microbiologics, St. Cloud, MN, USA);
- Staphylococcus aureus (ATCC 6538, Microbiologics, St. Cloud, MN, USA);
- Aspergillus niger (ATCC 6275, Microbiologics, St. Cloud, MN, USA);
- Chaetomium globosum (ATCC 6205, Microbiologics, St. Cloud, MN, USA).
2.1.3. Cell Culture
2.2. Methods
2.2.1. Magnetron Sputtering
2.2.2. SEM/EDS—Scanning Electron Microscopy/Energy-Dispersive X-ray Spectroscopy
2.2.3. Atomic Absorption Spectrometry with Flame Excitation—FAAS
2.2.4. Biological Experiments
Antibacterial Activity
Antifungal Activity
2.2.5. Cytotoxicity
Cell Culture
Extract Preparation and Cell Treatment
The Neutral Red Uptake (NRU) Assay
3. Results and Discussion
3.1. SEM/EDS—Scanning Electron Microscopy/Energy-Dispersive X-ray Spectroscopy
3.2. Atomic Absorption Spectrometry with Flame Excitation—FAAS
3.3. Antimicrobial Properties
3.3.1. Antibacterial Activity
3.3.2. Antifungal Activity
3.4. Cytotoxicity
3.5. Cytotoxicity Experiments
4. Conclusions
Author Contributions
Funding
Institutional Review Board Statement
Informed Consent Statement
Data Availability Statement
Acknowledgments
Conflicts of Interest
References
- Scopus Base: 20249 Document Results on Cotton Textiles. Available online: https://www-1scopus-1com-1000014110125.han.p.lodz.pl/results/results.uri?sid=1bbc482d0ac5c58eb43794f6882e404d&src=s&sot=b&sdt=b&origin=searchbasic&rr=&sl=30&s=TITLE-ABS-KEY(cotton%20textiles)&searchterm1=cotton%20textiles&searchTerms=&connectors=&field1=TITLE_ABS_KEY&fields=# (accessed on 3 March 2022).
- Wilson, J.F.; Toms, S.; Wong, N.D. (Eds.) The Cotton and Textile Industry: Innovation and Maturity: Case Studies in Industrial History; Taylor & Francis: London, UK, 2021; pp. 1–99. ISBN 9780429399749. [Google Scholar]
- Patterson, G. Cellulose before CELL: Historical themes. Carbohydr. Polym. 2021, 252, 117182. [Google Scholar] [CrossRef] [PubMed]
- Klemm, D.; Heublein, B.; Fink, H.-P.; Bohn, A. Cellulose: Fascinating biopolymer and sustainable raw material. Angew. Chem. Int. Ed. 2005, 44, 3358–3393. [Google Scholar] [CrossRef] [PubMed]
- Klemm, D.; Kramer, F.; Moritz, S.; Lindstrom, T.; Ankerfors, M.; Gray, D.; Dorris, A. Nanocelluloses: A new family of nature-based materials. Angew. Chem. Int. Ed. 2011, 50, 5438–5466. [Google Scholar] [CrossRef] [PubMed]
- Belgacem, M.N.; Gandini, A. (Eds.) Monomers, Polymers & Composites from Renewable Resources; Elsevier Science: Amsterdam, The Netherlands, 2008; ISBN 9780080453163. [Google Scholar]
- Kolárová, K.; Vosmanská, V.; Rimpelová, S.; Švorcík, V. Physical-chemical properties of cellulose-based materials and its antibacterial properties in Cellulose and Cellulose Derivatives: Synthesis, Modification and Applications; Mondal, I.H., Ed.; Nova Science Publisher: Hauppauge, NY, USA, 2015; Chapter 20; pp. 421–454. [Google Scholar]
- Singh, S.P.; Soni, B.; Bajpai, S.K. Chemically Modified Cotton Fibers for Antimicrobial Applications (Book Chapter) in Cellulose-Based Graft Copolymers: Structure and Chemistry; Thakur, V.K., Ed.; CRC Press Taylor & Francis Group: Boca Raton, FL, USA; London, UK; New York, NY, USA, 2015; pp. 235–270. [Google Scholar]
- Rojas, O.J. (Ed.) Cellulose Chemistry and Properties: Fibers, Nanocelluloses and Advanced Materials; Springer Int. Pub.: Heidelberg, Switzerland; New York, NY, USA; Dordrecht, Switzerland; London, UK, 2016; Volume 271, ISBN 978-3-319-26015-0. [Google Scholar]
- Rol, F.; Belgacem, M.; Gandini, A.; Bras, J. Recent advances in surface-modified cellulose nanofibrils. Prog. Polym. Sci. 2019, 88, 241–264. [Google Scholar] [CrossRef]
- Ageorges, V.; Monteiro, R.; Leroy, S.; Burgess, C.M.; Pizza, M.; Chaucheyras-Durand, F.; Desvaux, M. Molecular determinants of surface colonisation in diarrhoeagenic Escherichia coli (DEC): From bacterial adhesion to biofilm formation. FEMS Microbiol. Rev. 2020, 44, 314–350. [Google Scholar] [CrossRef] [PubMed]
- Granados, A.; Pleixats, R.; Vallribera, A. Recent advances on antimicrobial and anti-inflammatory cotton fabrics containing nanostructures. Molecules 2021, 26, 3008. [Google Scholar] [CrossRef]
- Varshney, S.; Sain, A.; Gupta, D.; Sharma, S. Factors affecting bacterial adhesion on selected textile fibres. Indian J. Microbiol. 2021, 61, 31–37. [Google Scholar] [CrossRef]
- Saidin, S.; Jumat, M.A.; Mohd Amin, N.A.A.; Saleh Al-Hammadi, A.S. Organic and inorganic antibacterial approaches in combating bacterial infection for biomedical application. Mater. Sci. Eng. C 2021, 118, 111382. [Google Scholar] [CrossRef]
- Teixeira, M.A.; Paiva, M.C.; Amorim, M.T.P.; Felgueira, H.P. Electrospun nanocomposites containing cellulose and its derivatives modified with specialized biomolecules for an enhanced wound healing. Nanomaterials 2020, 10, 557. [Google Scholar] [CrossRef] [Green Version]
- Wang, C.-Y.; Makvandi, P.; Zare, E.N.; Tay, F.R.; Niu, L.-N. Advances in antimicrobial organic and inorganic nanocompounds in biomedicine. Adv. Therap. 2020, 3, 2000024. [Google Scholar] [CrossRef]
- El-Alfy, E.A.; El-Bisi, M.K.; Taha, G.M.; Ibrahim, H.M. Preparation of biocompatible chitosan nanoparticles loaded by tetracycline, gentamycin and ciprofloxacin as novel drug delivery system for improvement the antibacterial properties of cellulose based fabrics. Int. J. Biol. Macromol. 2020, 161, 1247–1260. [Google Scholar] [CrossRef] [PubMed]
- Bodor, N.; Kaminski, J.J.; Selk, S. Soft drugs. 1. Labile quaternary ammonium salts as soft antimicrobials. J. Med. Chem. 1980, 23, 469–474. [Google Scholar] [CrossRef] [PubMed]
- Tischer, M.; Pradel, G.; Ohlsen, K.; Holzgrabe, U. Quaternary Ammonium Salts and Their Antimicrobial Potential: Targets or Nonspecific Interactions? ChemMedChem 2012, 7, 22–31. [Google Scholar] [CrossRef] [PubMed]
- Kwaśniewska, D.; Chen, Y.L.; Wieczorek, D. Biological activity of quaternary ammonium salts and their derivatives. Pathogens 2020, 9, 459. [Google Scholar] [CrossRef]
- Yeow, J.; Shanmugam, S.; Corrigan, N.; Kuchel, R.P.; Xu, J.; Boyer, C. A Polymerization-induced self-assembly approach to nanoparticles loaded with singlet oxygen generators. Macromolecules 2016, 49, 7277–7285. [Google Scholar] [CrossRef]
- Blacha-Grzechnik, A. New Approach in the Application of Conjugated Polymers: The Light-Activated Source of Versatile Singlet Oxygen Molecule. Materials 2021, 14, 1098. [Google Scholar] [CrossRef]
- Sun, G.; Worley, S.D. Halamine Chemistry and its Applications in Biocidal Textiles and Polymers. In Modified Fibers with Medical and Specialty Applications; Edwards, J.V., Buschle-Diller, G., Goheen, S.C., Eds.; Springer: Dordrecht, The Netherlands, 2006. [Google Scholar] [CrossRef]
- Scopus Base: 7.673 Document Results on Antibacterial Zinc. Available online: https://www-1scopus-1com-100001411012f.han.p.lodz.pl/results/results.uri?sid=94895d0abb0adeb79616d9f4561396f8&src=s&sot=b&sdt=b&origin=searchbasic&rr=&sl=34&s=TITLE-ABS-KEY(Antibacterial%20%20Zinc)&searchterm1=Antibacterial%20%20Zinc&searchTerms=&connectors=&field1=TITLE_ABS_KEY&fields= (accessed on 3 March 2022).
- Vallee, B.L.; Falchuk, K.H. The biochemical basis of zinc physiology. Physiol. Rev. 1993, 73, 79–118. [Google Scholar] [CrossRef]
- Fosmire, G.J. Zinc toxicity. Am. J. Clin. Nutr. 1990, 51, 225–227. [Google Scholar] [CrossRef]
- Cheknev, S.B.; Vostrova, E.I.; Apresova, M.A.; Piskovskaya, L.S.; Vostrov, A.V. Deceleration of bacterial growth in Staphylococcus aureus and Pseudomonas aeruginosa cultures in the presence of copper and zinc cations. Zh. Mikrobiol. Epidemiol. Immunobiol. 2015, 2, 9–17. [Google Scholar]
- Nakashima, T.; Sakagami, Y.; Matsuo, M. Antibacterial efficacy of cotton fabrics chemically modified by metal salts. Biocontrol Sci. 2001, 6, 9–15. [Google Scholar] [CrossRef]
- Ibrahim, N.A.; Gouda, M.; Zairy, W.M. Enhancing easy care and antibacterial functions of cellulose/wool blends. J. Nat. Fibers 2008, 5, 347–365. [Google Scholar] [CrossRef]
- Ibrahim, N.A.; Eid, B.M.; Youssef, M.A.; El-Sayed, S.A.; Salah, A.M. Functionalization of cellulose-containing fabrics by plasma and subsequent metal salt treatments. Carbohyd. Polym. 2012, 90, 908–914. [Google Scholar] [CrossRef] [PubMed]
- Higazy, A.; Hashem, M.; ElShafei, A.; Shaker, N.; Hady, M.A. Development of anti-microbial jute fabrics via in situ formation of cellulose-tannic acid-metal ion complex. Carbohyd. Polym. 2010, 79, 890–897. [Google Scholar] [CrossRef]
- Shankar, S.; Teng, X.; Li, G.; Rhim, J.-W. Preparation, characterization, and antimicrobial activity of gelatin/ZnO nanocomposite films. Food Hydrocoll. 2015, 45, 264–271. [Google Scholar] [CrossRef]
- Shankar, S.; Rhim, J.-W. Effect of Zn salts and hydrolyzing agents on the morphology and antibacterial activity of zinc oxide nanoparticles. Environ. Chem. Lett. 2019, 17, 1105–1109. [Google Scholar] [CrossRef]
- Perelshtein, I.; Perkas, N.; Gedanken, A. Ultrasonic coating of textiles by antibacterial and antibiofilm nanoparticles #31 (Book Chapter). In Handbook of Ultrasonics and Sonochemistry; Springer: Singapore, 2016; pp. 967–993. [Google Scholar]
- Lotfiman, S.; Ghorbanpour, M. Antimicrobial activity of ZnO/silica gel nanocomposites prepared by a simple and fast solid-state method. Surf. Coat. Technol. 2017, 310, 129–133. [Google Scholar] [CrossRef]
- Pandimurugan, R.; Thambidurai, S. UV protection and antibacterial properties of seaweed capped ZnO nanoparticles coated cotton fabrics. Int. J. Biol. Macromol. 2017, 105, 788–795. [Google Scholar] [CrossRef]
- Wang, S.; Yang, Y.; Lu, A.; Zhang, L. Construction of cellulose/ZnO composite microspheres in NaOH/zinc nitrate aqueous solution via one-step method. Cellulose 2019, 26, 557–568. [Google Scholar] [CrossRef]
- Jones, N.; Ray, B.; Ranjit, K.T.; Manna, A.C. Antibacterial activity of ZnO nanoparticle suspensions on a broad spectrum of microorganisms. FEMS Microbiol. Lett. 2008, 279, 71–76. [Google Scholar] [CrossRef] [Green Version]
- Hoseinnejad, M.; Jafari, S.M.; Katouzian, I. Inorganic and metal nanoparticles and their antimicrobial activity in food packaging applications. Crit. Rev. Microbiol. 2018, 44, 161–181. [Google Scholar] [CrossRef]
- Yuvasravana, R.; George, P.P.; Devanna, N.; Apsana, G. Fabrication and comparison between anti-bacterial properties of metal oxide nanoparticles prepared by a biogenic approach. J. Bionanosci. 2018, 12, 408–416. [Google Scholar] [CrossRef]
- Li, Y.; Liao, C.; Tjong, S.C. Recent advances in zinc oxide nanostructures with antimicrobial activities. Int. J. Mol. Sci. 2020, 21, 8836. [Google Scholar] [CrossRef] [PubMed]
- Geetha, P. Antibacterial and anticancer activities of biogenic synthesized Ag and ZnO NPS. Int. J. Innov. Technol. Expl. Eng. 2019, 8, 3143–3147. [Google Scholar] [CrossRef]
- Hu, H.; Yu, L.; Qian, X.; Chen, Y.; Chen, B.; Li, Y. Chemoreactive nanotherapeutics by metal peroxide based nanomedicine. Adv. Sci. 2021, 8, 2000494. [Google Scholar] [CrossRef]
- Sirelkhatim, A.; Mahmud, S.; Seeni, A.; Kaus, N.H.M.; Ann, L.C.; Bakhori, S.K.M.; Hasan, H.; Mohamad, D. Review on zinc oxide nanoparticles: Antibacterial activity and toxicity mechanism. Nano-Micro Lett. 2015, 7, 219–242. [Google Scholar] [CrossRef] [Green Version]
- Durrant, P.J.; Durrant, B. Introduction to Advanced Inorganic Chemistry; Chapter 16. Group IIB element, zinc; Longman, Green &Co. Ltd.: London, UK, 1962; pp. 508–522. ISBN 0582442133/9780582442139. [Google Scholar]
- Weibel, D.; Jovanovic, Z.R.; Gálvez, E.; Steinfeld, A. Mechanism of Zn particle oxidation by H2O and CO2 in the presence of ZnO. Chem. Mater. 2014, 26, 6486–6495. [Google Scholar] [CrossRef]
- Gunawan, L.; Johari, G.P. Specific heat, melting, crystallization, and oxidation of zinc nanoparticles and their Transmission Electron Microscopy studies. J. Phys. Chem. C 2008, 112, 20159–20166. [Google Scholar] [CrossRef]
- Khanlary, M.R.; Vahedi, V.; Reyhani, A. Synthesis and characterization of ZnO nanowires by thermal oxidation of Zn thin films at various temperatures. Molecules 2012, 17, 5021–5029. [Google Scholar] [CrossRef] [Green Version]
- Cox, J.D.; Wagman, D.D.; Medvedev, V.A. CODATA Key Values for Thermodynamics; Hemisphere Publishing Corp.: New York, NY, USA, 1984; Volume 1. [Google Scholar]
- Leitner, J.; Kamrádek, M.; Sedmidubský, D. Thermodynamic properties of rock-salt ZnO. Thermochim. Acta 2013, 572, 1–5. [Google Scholar] [CrossRef]
- Li, Y.; Wu, X. The standard molar enthalpies of formation of nano-ZnO particles with different morphologies. J. Nanomater. 2015, 16, 738909. [Google Scholar] [CrossRef]
- Ellmer, K.; Klein, A. ZnO and Its Applications. In Transparent Conductive Zinc Oxide; Ellmer, K., Klein, A., Rech, B., Eds.; Springer Series in Materials Science; Springer: Berlin/Heidelberg, Germany, 2008; Volume 104. [Google Scholar] [CrossRef]
- Tan, X.-Q.; Liu, J.-Y.; Niu, J.-R.; Liu, J.-Y.; Tian, J.-Y. Recent progress in magnetron sputtering technology used on fabrics. Materials 2018, 11, 1953. [Google Scholar] [CrossRef] [PubMed] [Green Version]
- Li, Y.; Niu, J.; Zhang, W.; Zhang, L.; Shang, E. Influence of aqueous media on the ROS-mediated toxicity of ZnO nanoparticles toward green fluorescent protein-expressing escherichia coli under UV-365 irradiation. Langmuir 2014, 30, 2852–2862. [Google Scholar] [CrossRef] [PubMed]
- Lakshmi Prasanna, V.; Vijayaraghavan, R. Insight into the mechanism of antibacterial activity of ZnO: Surface defects mediated reactive oxygen species even in the dark. Langmuir 2015, 31, 9155–9162. [Google Scholar] [CrossRef] [PubMed]
- Kim, H.R.; Lee, D.; Lee, G.H.; Kim, S.K.; Choi, S.J.; Hwang, E.T.; Maharjan, A.; Kim, B.S.; Kim, D.; Joo, J.H. Origin of Antibacterial Activity of ZnO Nanoparticles: The Roles of Protonic and Electronic Conductions. Part. Part. Syst. Charact. 2019, 36, 1900141. [Google Scholar] [CrossRef]
- Pachaiappan, R.; Rajendran, S.; Show, P.L.; Manavalan, K.; Naushad, M. Metal/metal oxide nanocomposites for bactericidal effect: A review. Chemosphere 2021, 272, 128607. [Google Scholar] [CrossRef]
- Li, M.; Zhu, L.; Lin, D. Toxicity of ZnO nanoparticles to escherichia Coli: Mechanism and the influence of medium components. Environ. Sci. Technol. 2011, 45, 1977–1983. [Google Scholar] [CrossRef]
- Hoseinzadeh, E.; Makhdoumi, P.; Taha, P.; Hossini, H.J.; Makhdoumi, P.; Kamal, M.A.; Ashraf, G. A review on nano-antimicrobials: Metal nanoparticles, methods and mechanisms. Curr. Drug Metab. 2017, 18, 120–128. [Google Scholar] [CrossRef]
- Danilova, T.A.; Danilina, G.A.; Adzhieva, A.A.; Vostrova, E.I.; Zhukhovitskii, V.G.; Cheknev, S.B. Inhibitory effect of copper and zinc ions on the growth of Streptococcus pyogenes and Escherichia coli Biofilms. Bull. Exp. Biol. Med. 2020, 169, 648–652. [Google Scholar] [CrossRef]
- Sapkota, A.; Anceno, A.J.; Baruah, S.; Shipin, O.V.; Dutta, J. Zinc oxide nanorod mediated visible light photoinactivation of model microbes in water. Nanotechnology 2011, 22, 215703. [Google Scholar] [CrossRef]
- Vigneshwaran, N.; Kumar, S.; Kathe, A.A.; Varadarajan, P.V.; Prasad, V. Functional finishing of cotton fabrics using zinc oxide-soluble starch nanocomposites. Nanotechnology 2006, 17, 5087–5095. [Google Scholar] [CrossRef]
- Perelshtein, I.; Applerot, G.; Perkas, N.; Wehrschetz-Sigl, E.; Hasmann, A.; Guebitz, G.M.; Gedanken, A. Antibacterial properties of an in situ generated and simultaneously deposited nanocrystalline ZnO on fabrics. ACS Appl. Mater. Interfaces 2009, 1, 361–366. [Google Scholar] [CrossRef] [PubMed]
- Petkova, P.; Francesko, A.; Fernandes, M.M.; Mendoza, E.; Ilana Perelshtein, I.; Gedanken, A.; Tzanov, T. Sonochemical coating of textiles with hybrid ZnO/chitosan antimicrobial nanoparticles. ACS Appl. Mater. Interfaces 2014, 6, 1164–1172. [Google Scholar] [CrossRef] [PubMed]
- Petkova, P.; Francesko, A.; Perelshtein, I.; Gedanken, A.; Tzanov, T. Simultaneous sonochemical-enzymatic coating of medical textiles with antibacterial ZnO nanoparticles. Ultrason. Sonochem. 2016, 29, 244–250. [Google Scholar] [CrossRef] [PubMed]
- Hu, R.; Yang, J.; Yang, P.; Wu, Z.; Xiao, H.; Liu, Y.; Lu, M. Fabrication of ZnO@Cotton fabric with anti-bacterial and radiation barrier properties using an economical and environmentally friendly method. Cellulose 2020, 27, 2901–2911. [Google Scholar] [CrossRef]
- Selvam, S.; Sundrarajan, M. Functionalization of cotton fabric with PVP/ZnO nanoparticles for improved reactive dyeability and antibacterial activity. Carbohydr. Polym. 2012, 87, 1419–1424. [Google Scholar] [CrossRef]
- Ugur, S.S.; Sariisik, M.; Aktas, A.H.; Ucar, M.C.; Erden, E. Modifying of cotton fabric surface with Nano-ZnO multilayer films by Layer-by-Layer deposition method. Nanoscale Res. Lett. 2010, 5, 1204–1210. [Google Scholar] [CrossRef] [Green Version]
- El-Naggar, M.E.; Hassabo, A.G.; Mohamed, A.L.; Shaheen, T.I. Surface modification of SiO2 coated ZnO nanoparticles for multifunctional cotton fabrics. J. Colloid Interf. Sci. 2017, 498, 413–422. [Google Scholar] [CrossRef]
- Shaheen, T.; El-Naggar, M.E.; Abdelgawad, A.M.; Hebeish, A. Durable antibacterial and UV protections of in situ synthesized zinc oxide nanoparticles onto cotton fabrics. Int. J. Biol. Macromol. 2016, 83, 426–432. [Google Scholar] [CrossRef]
- Shaban, M.; Mohamed, F.; Abdallah, S. Production and characterization of superhydrophobic and antibacterial coated fabrics utilizing ZnO nanocatalyst. Sci. Rep. 2018, 8, 3925. [Google Scholar] [CrossRef]
- Shateri-Khalilabad, M.; Yazdanshenas, M.E. Bifunctionalization of cotton textiles by ZnO nanostructures: Antimicrobial activity and ultraviolet protection. Text. Res. J. 2013, 83, 993–1004. [Google Scholar] [CrossRef]
- Fouda, A.; EL-Din Hassan, S.; Salem, S.S.; Shaheen, T.I. In-Vitro cytotoxicity, antibacterial, and UV protection properties of the biosynthesized Zinc oxide nanoparticles for medical textile applications. Microb. Pathog. 2018, 125, 252–261. [Google Scholar] [CrossRef] [PubMed]
- Musil, J.; Vlcek, J. Magnetron sputtering of films with controlled texture and grain size. Mater. Chem. Phys. 1998, 54, 116–122. [Google Scholar] [CrossRef]
- Kelly, P.; Arnell, R.D. Magnetron Sputtering: A Review of Recent Developments and Applications. Vacuum 2000, 56, 159–172. [Google Scholar] [CrossRef]
- Dinescu, G.; Ruset, C.; Dinescu, M. Trends in combining techniques for the deposition of new application-tailored thin films. Plasma Process. Polym. 2007, 4, 282–292. [Google Scholar] [CrossRef]
- Shahidi, S.; Ghoranneviss, M.; Moazzenchi, B.; Rashidi, A.; Mirjalili, M. Investigation of antibacterial activity on cotton fabrics with cold plasma in the presence of a magnetic field. Plasma Process. Polym. 2007, 4, 1098–1103. [Google Scholar] [CrossRef]
- Han, J.G. Recent progress in thin film processing by magnetron sputtering with plasma diagnostics. J. Phys. D Appl. Phys. 2009, 42, 043001. [Google Scholar] [CrossRef]
- Gorberg, B.L.; Ivanov, A.A.; Mamontov, O.V.; Stegnin, V.A.; Titov, V.A. Modification of textile materials by the deposition of nanocoatings by magnetron ion-plasma sputtering. Russ. J. Gen. Chem. 2013, 83, 157–163. [Google Scholar] [CrossRef]
- Zhang, H.; Cherng, J.-S.; Chen, Q. Recent progress on high power impulse magnetron sputtering (HiPIMS): The challenges and applications in fabricating VO2 thin film. AIP Adv. 2019, 9, 035242. [Google Scholar] [CrossRef] [Green Version]
- Scopus Base: 11805 Document Results on Zinc Sputtering. Available online: https://www-1scopus-1com-10000141101be.han.p.lodz.pl/results/results.uri?sid=45b2d096db1d5d687abc015e8271c5b8&src=s&sot=b&sdt=b&origin=searchbasic&rr=&sl=30&s=TITLE-ABS-KEY(zinc%20sputtering)&searchterm1=zinc%20sputteringsearchTerms=&connectors=&field1=TITLE_ABS_KEY&fields= (accessed on 3 March 2022).
- Scopus Base: 289 Document Results on Polymer Zinc Sputtering. Available online: https://www-1scopus-1com-10000141101be.han.p.lodz.pl/results/results.uri?sid=d4411dea1a4b0222c939239a6a49e873&src=s&sot=b&sdt=b&origin=searchbasic&rr=&sl=38&s=TITLE-ABS-KEY(polymer%20zinc%20sputtering)&searchterm1=polymer%20zinc%20sputtering&searchTerms=&connectors=&field1=TITLE_ABS_KEY&fields= (accessed on 3 March 2022).
- Bachari, E.M.; Ben Amor, S.; Baud, G.; Jacquet, M. Photoprotective zinc oxide coatings on polyethylene terephthalate films. Mater. Sci. Eng. B Solid State Mater. Adv. Technol. 2001, 79, 165–174. [Google Scholar] [CrossRef]
- Koidis, C.; Logothetidis, S.; Georgiou, D.; Laskarakis, A.; Lousinian, S.; Tsiaoussis, I.; Frangis, N. Growth, optical and nanostructural properties of magnetron sputtered ZnO thin films deposited on polymeric substrates. Phys. Status Solidi A 2008, 205, 1988–1992. [Google Scholar] [CrossRef]
- Amor, S.B.; Jacquet, M.; Fioux, P.; Nardin, M. XPS characterisation of plasma treated and zinc oxide coated PET. Appl. Surf. Sci. 2009, 255, 5052–5061. [Google Scholar] [CrossRef]
- Garganourakis, M.; Logothetidis, S.; Pitsalidis, C.; Georgiou, D.; Kassavetis, S.; Laskarakis, A. Deposition and characterization of PEDOT/ZnO layers onto PET substrates. Thin Solid Films 2009, 517, 6409–6413. [Google Scholar] [CrossRef]
- Ben Amor, S.; Jacquet, M.; Fioux, P.; Nardin, M. A ZnO/PET assembly study: Optimization and investigation of the interface region. Mater. Chem. Phys. 2010, 119, 158–168. [Google Scholar] [CrossRef]
- Sierros, K.A.; Banerjee, D.A.; Morris, N.J.; Cairns, D.R.; Kortidis, I.; Kiriakidis, G. Mechanical properties of ZnO thin films deposited on polyester substrates used in flexible device applications. Thin Solid Films 2010, 519, 325–330. [Google Scholar] [CrossRef]
- Fahlteich, J.; Schönberger, W.; Fahland, M.; Schiller, N. Characterization of reactively sputtered permeation barrier materials on polymer substrates. Surf. Coat. Technol. 2011, 205 (Suppl. 2), S141–S144. [Google Scholar] [CrossRef]
- Wang, S.S.; Yang, C.B.; Shiou, F.J.; Hsu, C.Y. Structural properties of Ga-doped ZnO films grown on polymer substrates. J. Comp. Theoret. Nanosci. 2014, 11, 751–756. [Google Scholar] [CrossRef]
- Imran, M.; Ahmad, R.; Afzal, N.; Rafique, M. Copper ion implantation effects in ZnO film deposited on flexible polymer by DC magnetron sputtering. Vacuum 2019, 165, 72–80. [Google Scholar] [CrossRef]
- Guedri-Knani, L.; Gardette, J.L.; Jacquet, M.; Rivaton, A. Photoprotection of poly(ethylene-naphthalate) by zinc oxide coating. Surf. Coat. Technol. 2004, 180–181, 71–75. [Google Scholar] [CrossRef]
- Guedri, L.; Ben Amor, S.; Gardette, J.L.; Jacquet, M.; Rivaton, A. Lifetime improvement of poly(ethylene naphthalate) by ZnO adhesive coatings. Polym. Degrad. Stab. 2005, 88, 199–205. [Google Scholar] [CrossRef]
- Liu, Y.-Y.; Yuan, Y.-Z.; Gao, X.-T.; Yan, S.; Cao, X.-Z.; Wei, G.-X. Deposition of ZnO thin film on polytetrafluoroethylene substrate by the magnetron sputtering method. Mater. Lett. 2007, 61, 4463–4465. [Google Scholar] [CrossRef]
- Liu, Y.-Y.; Yuan, Y.-Z.; Li, C.-F.; Gao, X.; Cao, X.-Z.; Li, J.-B. The structure and photoluminescence properties of RF-sputtered films of ZnO on Teflon substrate. Mater. Lett. 2008, 62, 2907–2909. [Google Scholar] [CrossRef]
- Liu, Y.-Y.; Zang, Y.-L.; Wei, G.-X.; Li, J.; Fan, X.-L.; Cheng, C.-F. Stress and structural studies of ZnO thin films on polymer substrate under different RF powered conditions. Mater. Lett. 2009, 63, 2597–2599. [Google Scholar] [CrossRef]
- Liu, Y.; Wang, R.; Wei, G.; Cui, D.; Wang, H. Effect of deposition pressure on the properties of zno films on teflon substrate by RF magnetron sputtering. Acta Microsc. 2019, 28, 391–396. [Google Scholar]
- Pál, E.; Seemann, T.; Zöllmer, V.; Busse, M.; Dékány, I. Hybrid ZnO/polymer thin films prepared by RF magnetron sputtering. Colloid Polym. Sci. 2009, 287, 481–485. [Google Scholar] [CrossRef]
- Wei, Q.; Yu, L.; Hou, D.; Huang, F. Surface characterization and properties of functionalized nonwoven. J. Appl. Polym. Sci. 2008, 107, 132–137. [Google Scholar] [CrossRef]
- Singh, A.; Schipmann, S.; Mathur, A.; Pal, D.; Sengupta, A.; Klemradt, U.; Chattopadhyay, S. Structure and morphology of magnetron sputter deposited ultrathin ZnO films on confined polymeric template. Appl. Surf. Sci. 2019, 414, 114–123. [Google Scholar] [CrossRef]
- Giancaterina, S.; Ben Amor, S.; Baud, G.; Gardette, J.L.; Jacquet, M.; Perrin, C.; Rivaton, A. Photoprotective ceramic coatings on poly(ether ether ketone). Polymer 2002, 43, 6397–6405. [Google Scholar] [CrossRef]
- Yoo, D.; Choi, M.-S.; Chung, C.; Heo, S.C.; Kim, D.; Choi, C. Characteristics of radio frequency-sputtered ZnS on the flexible polyethylene terephthalate (PET) substrate. J. Nanosci. Nanotechnol. 2013, 13, 7814–7819. [Google Scholar] [CrossRef]
- Fortunato, E.; Godinho, M.H.; Santos, H.; Marques, A.; Assunção, V.; Pereira, L.; Águas, H.; Ferreira, I.; Martins, R. Surface modification of a new flexible substrate based on hydroxypropylcellulose for optoelectronic applications. Thin Solid Films 2003, 442, 127–131. [Google Scholar] [CrossRef]
- Wei, Q.; Xu, Q.; Cai, Y.; Gao, W.; Bo, C. Characterization of polymer nanofibers coated by reactive sputtering of zinc. J. Mater. Process. Technol. 2009, 209, 2028–2032. [Google Scholar] [CrossRef]
- Pertsin, A.I.; Volkov, I.O. Interaction of zinc atoms with polymer surfaces. Vysokomol. Soed. Ser. A 1996, 38, 1249–1253. [Google Scholar]
- Kudzin, M.H.; Mrozinska, Z.; Urbaniak, P. Vapor phosphorylation of cellulose by phosphorus trichloride: Selective phosphorylation of 6-hydroxyl function—The synthesis of new antimicrobial Cellulose 6-Phosphate(III)-Copper complexes. Antibiotics 2021, 10, 203. [Google Scholar] [CrossRef] [PubMed]
- Kudzin, M.H.; Mrozińska, Z.; Łatwińska, M.; Urbaniak, P.; Drabowicz, J. Stability of cellulose phosphates in alkalic solutions. Phosphorus Sulfur Silicon Relat. Elem. 2022. [Google Scholar] [CrossRef]
- Kudzin, M.H.; Mrozińska, Z.; Urbaniak, P.; Drabowicz, J. Surface phosphorylation of cellulose by means of PCl3 and P(O)Cl3. Phosphorus Sulfur Silicon Relat. Elem. 2021. [Google Scholar] [CrossRef]
- Kudzin, M.H.; Giełdowska, M.; Krata, A.A.; Sulak, E.; Urbaniak, P.; Drabowicz, J. Surface phosphorylation of chitosan by means of PCl3. Phosphorus Sulfur Silicon Relat. Elem. 2021. [Google Scholar] [CrossRef]
- Kudzin, M.H.; Mrozinska, Z. Biofunctionalization of textile materials. 3. Biofunctionalization of poly(lactide) (PLA) nonwovens fabrics by KI. Coatings 2020, 10, 593. [Google Scholar] [CrossRef]
- Kudzin, M.H.; Mrozinska, Z.; Walawska, A.; Sójka-Ledakowicz, J. Biofunctionalization of textile materials.1. Biofunctionalization of poly(propylene) (PP) nonwovens fabrics by Alafosfalin. Coatings 2019, 9, 412. [Google Scholar] [CrossRef] [Green Version]
- Kudzin, M.H.; Mrozinska, Z. Biofunctionalization of textile materials. 2. Antimicrobial modification of poly(lactide) (PLA) nonwoven fabrics by fosfomycin. Polymers 2020, 12, 768. [Google Scholar] [CrossRef] [Green Version]
- Kudzin, M.H.; Kudzin, Z.H.; Drabowicz, J. Thioureidoalkylphosphonates in the synthesis of 1-aminoalkylphosphonic acids. The Ptc-aminophosphonate method. Arkivoc 2011, 6, 227–269. [Google Scholar] [CrossRef] [Green Version]
- Drabowicz, J.; Jakubowski, H.; Kudzin, M.H.; Kudzin, Z.H. The nomenclature of 1-aminoalkylphosphonic acids and derivatives: Evolution of the code system. Acta Biochim. Pol. 2015, 62, 139–150. [Google Scholar] [CrossRef]
- Analytical Methods for Atomic Absorption Spectroscopy; The Perkin-Elmer Corporation: Waltham, MA, USA, 1996; Volume 46, Available online: www.perkinelmer.com (accessed on 3 July 2020).
- EN ISO 20645:2006; Textile Fabrics. Determination of Antibacterial Activity—Agar Diffusion Plate Test. International Organization for Standardization: Geneva, Switzerland, 2006.
- EN 14119:2005; Testing of Textiles. Evaluation of the Action of Microfungi. Visual Method. International Organization for Standardization: Geneva, Switzerland, 2005.
- EN 1ISO 10993-12:2012; Biological evaluation of medical devices—Part 12: Sample preparation and reference materials. International Organization for Standardization: Geneva, Switzerland, 2012.
- Panchakarla, L.S.; Govindaraj, A.; Rao, C.N.R. Formation of ZnO nanoparticles by the reaction of zinc metal with aliphatic alcohols. J. Clust. Sci. 2007, 18, 660–670. [Google Scholar] [CrossRef]
- Shah, M.A. Formation of zinc oxide nanoparticles by the reaction of zinc metal with methanol at very low temperature. Afr. Phys. Rev. 2008, 2, 106–109. [Google Scholar]
- Shah, M.A. Growth of zinc oxide nanoparticles by the reaction of zinc with ethanol. In Advanced Materials Research; Trans Tech Publications, Ltd.: Freienbach, Switzerland, 2009; Volume 67, pp. 215–219. [Google Scholar] [CrossRef]
- Shah, M.A. Synthesis of zinc oxide nanoparticles by the reaction of zinc metal with ethanol. Mod. Phys. Lett. B 2009, 23, 871–876. [Google Scholar] [CrossRef]
- Ekem, N.; Korkmaz, S.; Pat, S.; Balbag, M.Z.; Cetin, E.N.; Ozmumcu, M. Some physical properties of ZnO thin films prepared by RF sputtering technique. Int. J. Hydrog. Energy 2009, 34, 5218–5222. [Google Scholar] [CrossRef]
- Fenske, F.; Fuhs, W.; Nebauer, E.; Schopke, A.; Selle, B.; Sieber, I. Transparent conductive ZnO:Al films by reactive co-sputtering from separate metallic Zn and Al targets. Thin Solid Films 1999, 343–344, 130–133. [Google Scholar] [CrossRef]
- Wasim, M.; Khan, M.R.; Mushtaq, M.; Neem, A.; Han, M.; Wei, Q. Surface modification of bacterial cellulose by copper and Zinc Oxide sputter coating for UV-resistance/antistatic/antibacterial characteristics. Coatings 2020, 10, 364. [Google Scholar] [CrossRef] [Green Version]
- Chao, L.-C.; Lin, C.-F.; Liau, C.-C. Effect of surface morphology of metallic zinc films deposited by ion beam sputter deposition on the formation of ZnO nanowires. Vacuum 2011, 86, 295–298. [Google Scholar] [CrossRef]
- Abdalkader, D.; Al-Saedi, F. Antibacterial Effect of Different Concentrations of Zinc Sulfate on Multidrug Resistant Pathogenic Bacteria. Syst. Rev. Pharm. 2020, 11, 282–288. [Google Scholar] [CrossRef]
- Jayandran, M.; Haneefa, M.M.; Balasubramanian, V. Synthesis, characterization and antimicrobial activities of turmeric curcumin and curcumin stabilized zinc nanoparticles—A green approach. Res. J. Pharm. Technol. 2015, 8, 445–451. [Google Scholar] [CrossRef]
- Khan, F.A.; Khan, Z.U.H.; Ma, J.; Khan, A.U.; Sohail, M.; Chen, Y.; Yang, Y.; Pan, X. An Astragalus membranaceus based eco-friendly biomimetic synthesis approach of ZnO nanoflowers with an excellent antibacterial, antioxidant and electrochemical sensing effect. Mater. Sci. Eng. 2021, 118, 111432. [Google Scholar] [CrossRef]
- Haghgoo, R.; Ahmadvand, M.; Nyakan, M.; Jafari, M. Antimicrobial efficacy of mixtures of nanosilver and zinc oxide eugenol against Enterococcus faecalis. J. Contemp. Dent. Pract. 2017, 18, 177–181. [Google Scholar] [CrossRef] [PubMed] [Green Version]
- Abu Ali, H.; Omar, S.N.; Darawsheh, M.D.; Fares, H. Synthesis, characterization and antimicrobial activity of zinc(II) ibuprofen complexes with nitrogen-based ligands. Synthesis, characterization and antimicrobial activity of zinc(II) ibuprofen complexes with nitrogen-based ligands. J. Coord. Chem. 2016, 69, 1110–1122. [Google Scholar] [CrossRef]
- Danial, E.N.; Yousef, J.M. Comparative studies between zinc oxide and manganese oxide nano-particle for their antimicrobial activities. J. Pure Appl. Microbiol. 2014, 8, 293–300. [Google Scholar]
- Senthilraja, A.; Krishnakumar, B.; Hariharan, R.; Sobral, A.J.F.N.; Surya, C.; John, N.A.A.; Shanthi, M. Synthesis and characterization of bimetallic nanocomposite and its photocatalytic, antifungal and antibacterial activity. Sep. Purif. Technol. 2018, 202, 373–384. [Google Scholar] [CrossRef]
- Negi, A.; Gangwar, R.; Vishwakarma, R.K.; Negi, D.S. Biogenic zinc oxide nanoparticles as an antibacterial, antifungal, and photocatalytic tool mediated via leaves of Girardinia diversifolia. Nanotechnol. Environ. Eng. 2022, 7, 223–233. [Google Scholar] [CrossRef]
- Mekky, A.E.; Farrag, A.A.; Hmed, A.A.; Sofy, A.R. Preparation of zinc oxide nanoparticles using aspergillus niger as antimicrobial and anticancer agents. J. Pure Appl. Microbiol. 2021, 15, 1547–1566. [Google Scholar] [CrossRef]
- Vidhya, E.; Vijayakumar, S.; Prathipkumar, S.; Praseetha, P.K. Green way biosynthesis: Characterization, antimicrobial and anticancer activity of ZnO nanoparticles. Gene Rep. 2020, 20, 100688. [Google Scholar] [CrossRef]
- Umavathi, S.; Ramya, M.; Padmapriya, C.; Gopinath, K. Green Synthesis of Zinc Oxide Nanoparticle Using Justicia procumbense Leaf Extract and Their Application as an Antimicrobial Agent. J. Biol. Act. Prod. Nat. 2020, 10, 153–164. [Google Scholar] [CrossRef]
- Muthuchamy, M.; Muneeswaran, T.; Rajivgandhi, G.; Christophe Quero, F.; Muthusamy, A.; Ji-Ming, S. Biologically synthesized copper and zinc oxide nanoparticles for important biomolecules detection and antimicrobial applications. Mater. Today Commun. 2020, 22, 100766. [Google Scholar] [CrossRef]
- Pillai, A.M.; Sivasankarapillai, V.S.; Rahdar, A.; Joseph, J.; Sadeghfar, F.; Anuf, R.; Rajesh, K.; Kyzas, G.Z. Green synthesis and characterization of zinc oxide nanoparticles with antibacterial and antifungal activity. J. Mol. Struct. 2020, 1211, 128107. [Google Scholar] [CrossRef]
- Sandhya, J.; Kalaiselvam, S. UV responsive quercetin derived and functionalized CuO/ZnO nanocomposite in ameliorating photocatalytic degradation of rhodamine B dye and enhanced biocidal activity against selected pathogenic strains. J. Environ. Sci. Health-Toxic/Hazard. 2021, 56, 835–848. [Google Scholar] [CrossRef] [PubMed]
- Alioui, H.; Bouras, O.; Bollinger, J.-C. Toward an efficient antibacterial agent: Zn- and Mg-doped hydroxyapatite nanopowders. J. Environ. Sci. Health-Toxic/Hazard. 2019, 54, 315–327. [Google Scholar] [CrossRef] [PubMed]
- Sun, X.; Yin, L.; Zhu, H.; Zhu, J.; Hu, J.; Luo, X.; Huang, H.; Fu, Y. Enhanced Antimicrobial Cellulose/Chitosan/ZnO Biodegradable Composite Membrane. Membranes 2022, 12, 239. [Google Scholar] [CrossRef] [PubMed]
- Suryanegar, L.; Fatriasari, W.; Zulfiana, D.; Anita, S.H.; Masruchin, N.; Gutari, S.; Kemala, T. Novel antimicrobial bioplastic based on PLA-chitosan by addition of TiO2 and ZnO. J. Environ. Health Sci. Eng. 2021, 19, 415–425. [Google Scholar] [CrossRef]
- Ibrahim, S.; El-Naggar, M.E.; Youssef, A.M.; Abdel-Aziz, M.S. Functionalization of polystyrene nanocomposite with excellent antimicrobial efficiency for food packaging application. J. Clust. Sci. 2020, 31, 1371–1382. [Google Scholar] [CrossRef]
- Odell, E.; Pertl, C. Zinc as a growth factor for Aspergillus sp. and the antifungal effects of root canal sealants. Oral Surg. Oral Med. Oral Pathol. Oral Radiol. Endod. 1995, 79, 82–87. [Google Scholar] [CrossRef]
- Kudzin, M.H.; Giełdowska, M.; Mrozinska, Z.; Bogun, M. Poly(lactic acid)/Zinc/Alginate Complex Material: Preparation and Antimicrobial Properties. Antibiotics 2021, 10, 1327. [Google Scholar] [CrossRef]
- Lam, S.-M.; Lim, C.-L.; Sin, J.-C.; Zeng, H.; Lin, H.; Li, H. Facile synthesis of MnO2/ZnO coated on cotton fabric for boosted antimicrobial, self-cleaning and photocatalytic activities under sunlight. Mater. Lett. 2021, 305, 130818. [Google Scholar] [CrossRef]
- Siddiqi, K.S.; ur Rahman, A.; Tajuddin; Husen, A. Properties of zinc oxide nanoparticles and their activity against microbes. Nanoscale Res. Lett. 2018, 13, 141. [Google Scholar] [CrossRef]
- Takahashi, H.; Koshi, K. Solubility and cell toxicity of cobalt, zinc and lead. Ind. Health 1981, 19, 47–59. [Google Scholar] [CrossRef] [Green Version]
- David, C.A.; Galceran, J.; Rey-Castro, C.; Puy, J.; Companys, E.; Salvador, J.; Monné, J.; Wallace, R.; Vakourov, A. Dissolution kinetics and solubility of ZnO nanoparticles followed by AGNES. J. Phys. Chem. C 2012, 116, 11758–11767. [Google Scholar] [CrossRef]
- Wu, F.; Harper, B.J.; Harper, S.L. Comparative dissolution, uptake, and toxicity of zinc oxide particles in individual aquatic species and mixed populations. Environ. Toxicol. Chem. 2019, 38, 591–602. [Google Scholar] [CrossRef] [PubMed] [Green Version]
- Cao, D.; Gong, S.; Shu, X.; Zhu, D.; Liang, S. Preparation of ZnO nanoparticles with high dispersibility based on oriented attachment (OA) process. Nanoscale Res. Lett. 2019, 14, 210. [Google Scholar] [CrossRef] [PubMed] [Green Version]
- Lee, W.; Yeop, J.; Heo, J.; Yoon, Y.J.; Park, S.Y.; Jeong, J.; Shin, Y.S.; Kim, J.W.; An, N.G.; Kim, D.S.; et al. High colloidal stability ZnO nanoparticles independent on solvent polarity and their application in polymer solar cells. Sci. Rep. 2020, 10, 18055. [Google Scholar] [CrossRef]
- Stoddart, M. (Ed.) Mammalian Cell Viability. Methods in Molecular Biology (Methods and Protocols); Humana Press: New York, NY, USA; Springer: Dordrecht, The Netherlands; Heidelberg, Germany; London, UK, 2011; Volume 740. [Google Scholar] [CrossRef]
- Riss, T.L.; Moravec, R.A.; Niles, A.L.; Duellman, S.; Benink, H.A.; Worzella, T.J.; Minor, L. Cell Viability Assays. In Assay Guidance Manual; Markossian, S., Grossman, A., Brimacombe, K., Arkin, M., Auld, D., Austin, C.P., Baell, J., Chung, T.D.Y., Coussens, N.P., Dahlin, J.L., et al., Eds.; Eli Lilly & Company and the National Center for Advancing Translational Sciences: Bethesda, MD, USA, 2016. [Google Scholar]
- Garcia-Hernando, M.; Benito-Lopez, F.; Basabe-Desmonts, L. Advances in Microtechnology for Improved Cytotoxicity Assessment. Front. Mater. 2020, 7, 582030. [Google Scholar] [CrossRef]
- Chiellini, F. Perspectives on: In vitro evaluation of biomedical polymers. J. Bioact. Compat. Polym. 2006, 21, 257–271. [Google Scholar] [CrossRef]
- Goldberg, M.; Langer, R.; Jia, X. Nanostructured materials for applications in drug delivery and tissue engineering. J. Biomater. Sci. Polym. Ed. 2007, 18, 241–268. [Google Scholar] [CrossRef] [Green Version]
- Hu, J.; Tang, Y.; Elmenoufy, A.H.; Xu, H.; Cheng, Z.; Yang, X. Nanocomposite-based photodynamic therapy strategies for deep tumor treatment. Small 2015, 11, 5860–5887. [Google Scholar] [CrossRef]
- Naskar, A.; Kim, K.-S. Recent advances in nanomaterial-based wound-healing therapeutics. Pharmaceutics 2020, 12, 499. [Google Scholar] [CrossRef]
- Yetisgin, A.A.; Cetinel, S.; Zuvin, M.; Kosar, A.; Kutlu, O. Therapeutic nanoparticles and their targeted delivery applications. Molecules 2020, 25, 2193. [Google Scholar] [CrossRef]
- Ali, E.S.; Sharker, S.M.; Islam, M.T.; Khan, I.N.; Shaw, S.; Rahman, A.; Uddin, S.J.; Shill, M.C.; Rehman, S.; Das, N.; et al. Targeting cancer cells with nanotherapeutics and nanodiagnostics: Current status and future perspectives. Cancer Biol. 2021, 69, 52–68. [Google Scholar] [CrossRef] [PubMed]
- Nikzamir, M.; Akbarzadeh, A.; Panahi, Y. An overview on nanoparticles used in biomedicine and their cytotoxicity. J. Drug Deliv. Sci. Technol. 2021, 61, 102316. [Google Scholar] [CrossRef]
- Sharma, S.; Sudhakara, P.; Singh, J.; Ilyas, R.A.; Asyraf, M.R.M.; Razman, M.R. Critical review of biodegradable and bioactive polymer composites for bone tissue engineering and drug delivery applications. Polymers 2021, 13, 2623. [Google Scholar] [CrossRef] [PubMed]
- Repetto, G.; del Peso, A.; Zurita, J.L. Neutral red uptake assay for the estimation of cell viability/cytotoxicity. Nat. Protoc. 2008, 3, 1125–1131. [Google Scholar] [CrossRef] [PubMed]
- Liao, C.; Jin, Y.; Li, Y.; Tjong, S.C. Interactions of zinc oxide nanostructures with mammalian cells: Cytotoxicity and photocatalytic toxicity. Int. J. Mol. Sci. 2020, 21, 6305. [Google Scholar] [CrossRef] [PubMed]
- Yang, H.; Liu, C.; Yang, D.; Zhang, H.; Xi, Z. Comparative study of cytotoxicity, oxidative stress and genotoxicity induced by four typical nanomaterials: The role of particle size, shape and composition. J. Appl. Toxicol. 2009, 29, 69–78. [Google Scholar] [CrossRef]
- Heng, B.C.; Zhao, X.; Xiong, S.; Ng, K.W.; Boey, F.Y.-C.; Loo, J.S.-C. Cytotoxicity of zinc oxide (ZnO) nanoparticles is influenced by cell density and culture format. Archiv. Toxicol. 2011, 85, 695–704. [Google Scholar] [CrossRef]
- Saptarshi, S.R.; Duschl, A.; Lopata, A.L. Biological reactivity of zinc oxide nanoparticles with mammalian test systems: An overview. Nanomedicine 2015, 10, 2075–2092. [Google Scholar] [CrossRef]
- Bisht, G.; Rayamajhi, S. ZnO Nanoparticles: A promising anticancer agent. Nanobiomedicine 2016, 3, 9. [Google Scholar] [CrossRef]
- Scherzad, A.; Meyer, T.; Kleinsasser, N.; Hackenberg, S. Molecular mechanisms of Zinc oxide Nanoparticle-induced genotoxicity short running title: Genotoxicity of ZnO NPs. Materials 2017, 10, 1427. [Google Scholar] [CrossRef] [Green Version]
- Cordani, M.; Somoza, Á. Targeting autophagy using metallic nanoparticles: A promising strategy for cancer treatment. Cell. Mol. Life Sci. 2019, 76, 1215–1242. [Google Scholar] [CrossRef] [PubMed] [Green Version]
- Czyżowska, A.; Barbasz, A. Cytotoxicity of zinc oxide nanoparticles to innate and adaptive human immune cells. J. Appl. Toxicol. 2021, 41, 1425–1437. [Google Scholar] [CrossRef] [PubMed]
- Mukherjee, S.; Shil, A.; Pal, K.; Pal, S.; Sikdar, M. Comparative evaluation of the antibacterial and cytotoxic activity of green synthesized and commercially available ZnO nanoparticles. Biomedicine 2021, 41, 565–575. [Google Scholar] [CrossRef]
- Alkhudhayri, A.A. A comparative cytotoxic study against breast cancer cells with nanoparticles and rods shaped structures. J. King Saud Univ. Sci. 2022, 34, 101797. [Google Scholar] [CrossRef]
- Gong, Y.; Ji, Y.; Liu, F.; Li, J.; Cao, Y. Cytotoxicity, oxidative stress and inflammation induced by ZnO nanoparticles in endothelial cells: Interaction with palmitate or lipopolysaccharide. J. Appl. Toxicol. 2017, 37, 895–901. [Google Scholar] [CrossRef] [PubMed]
- Yan, D.; Long, J.; Liu, J.; Cao, Y. The toxicity of ZnO nanomaterials to HepG2 cells: The influence of size and shape of particles. J. Appl. Toxicol. 2019, 39, 231–240. [Google Scholar] [CrossRef]
- Liebsch, H.M.; Spielmann, H. Balb/c 3T3 cytotoxicity test. Methods Mol. Biol. 1995, 43, 177–187. [Google Scholar] [CrossRef]
- Rasmussen, J.W.; Martinez, E.; Louka, P.; Wingett, D.G. Zinc oxide nanoparticles for selective destruction of tumor cells and potential for drug delivery applications. Expert Opin. Drug Deliv. 2010, 7, 1063–1077. [Google Scholar] [CrossRef] [Green Version]
- Vakayil, R.; Muruganantham, S.; Kabeerdass, N.; Rajendran, M.; Mahadeopalve, A.; Ramasamy, S.; Alahmadi, T.A.; Almoallim, H.S.; Manikandan, V.; Mathanmohun, M. Acorus calamus-zinc oxide nanoparticle coated cotton fabrics shows antimicrobial and cytotoxic activities against skin cancer cells. Process Biochem. 2021, 111, 1–8. [Google Scholar] [CrossRef]
- Zhang, Y.; Guo, C.; Liu, L.; Xu, J.; Jiang, H.; Li, D.; Lan, J.; Li, J.; Yang, J.; Tu, Q.; et al. ZnO-based multifunctional nanocomposites to inhibit progression and metastasis of melanoma by eliciting antitumor immunity via immunogenic cell death. Theranostics 2020, 10, 11197–11214. [Google Scholar] [CrossRef]
- Scopus Base: 2 385 document results on Anticancer Zinc. Available online: https://www-1scopus-1com-1000014xv00bf.han.p.lodz.pl/results/results.uri?sort=plf-f&src=s&st1=anticancer+++zinc&sid=99008ee26e21b10041dcc27109299b0d&sot=b&sdt=b&sl=32&s=TITLE-ABS-KEY%28anticancer+++zinc%29&origin=searchbasic&editSaveSearch=&yearFrom=Before+1960&yearTo=Present (accessed on 3 March 2022).
- Scopus Base: 1695 document results on Anticancer Activity of Zinc. Available online: https://www-1scopus-1com-1000014rj027e.han.p.lodz.pl/results/results.uri?sort=plf-f&src=s&st1=anticancer+activity+of+zinc&sid=346666e547acd8834d6266afbda418b8&sot=b&sdt=b&sl=42&s=TITLE-ABS-KEY%28anticancer+activity+of+zinc%29&origin=searchbasic&editSaveSearch=&yearFrom=Before+1960&yearTo=Present (accessed on 3 March 2022).

| No | Preparation | Antibacterial Activity | Ref. |
|---|---|---|---|
| 2.1 | COT–ZnO (Zn2+(NaOH)→Zn(OH)2→ZnO) ZnO deposition by ‘pad–dry–cure’ method. | COT–ZnO showed excellent antibacterial activity against Kp and Sa, e.g., COT–ZnO (1.6%) exhibited 99.9%rv after 24 h exposure. Application onto cotton fabrics to impart antibacterial and UV protection function. | [62] |
| 2.2 | COT–ZnO (Zn2+(NH3ˣH2O)→Zn(OH)2→ZnO) ZnO deposition by ultrasound irradiation. | COT–ZnO showed excellent antibacterial activity against Kp and Sa, e.g., COT–ZnO (0.8%) exhibited 99.9%rv after 2 h exposure. Potential application as coated bandages. | [63] |
| 2.3 | COT–CTS (0.3%)–ZnO (0.2–2 mM) ZnO one-step sonochemical deposition on COT/CTS | Enhanced antimicrobial effect (Sa (98.5% rv) and Ec (99.9%rv)) after 1 h incubation and high washing stability enable recommending this antibacterial textile for uses in a hospital environment to prevent the spread of nosocomial infection | [64] |
| 2.4 | COT–ZnO (0.8%) (COT + ZnO NPs (1 mM)+ C-ase (2%)), ZnO sonochemical coating. | The antibacterial efficiency of COT–ZnO (Ec 67% and Sa 100% after 1 h incubation) resisted the intensive laundry regimes used in hospitals. | [65] |
| 2.5 | COT–ZnO | In situ nanoscale synthesis of ZnO on the surface of cotton fabrics (COT + ZnCl2 + NaOH→COT–ZnO) led to high antibacterial activity against Ec and Ec. | [66] |
| 2.6 | COT–ZnO; COT–PVP–ZnO | The antibacterial efficiency of COT–ZnO after 2 h incubation: COT–ZnO (5 mg/L)—Ec, 81%rv and Sa, 57%rv; COT–PVP–ZnO (5 mg/L)—Ec, 80%rv and Sa, 71%rv; COT–PVP–ZnO (20 mg/L)—Ec, 100%rv and Sa, 100%rv. Potential application as wound cloths, surgical cloths, sportswear and kidswear. | [67] |
| 2.7 | COT–R–N+Me3–ZnO/ZnO | Nano-ZnO films deposited on cotton fabrics (10–16 layers) exhibited excellent antimicrobial activity against Sa. | [68] |
| 2.8 | COT–ZnO; COT–BTCA–SiO2–ZnO; COT–APTES–BTCA–SiO2–ZnO; COT–VTES–SiO2–ZnO; | The antibacterial efficiency of hybrids varied for Ec from 96%rv to 99%rv and for Sa from 55%rv to 90%rv; after 20 washing cycles, it varied for Ec from 57%rv to 91%rv and for Sa from 55%rv to 90%rv. Multi-application potential. | [69] |
| 2.9 | COT–ZnO (Zn2+(HMTETA, H2O)→ZnO) | The antibacterial efficiency of hybrids after 24 h exposure varied for Ec from 91%rv to 97%rv and for Sa from 95%rv to 98%rv. | [70] |
| 2.10 | COT–ZnO (Zn2+(MMA, EtOEtOH)→ZnO) ZnO coating by a spin coater. | The antibacterial activities of the ZnO-coated fabric were investigated (zone inhibition diameter) against Kp, St (36 mm), Ec (19 mm), Bs (17 mm), and St (20 mm) using 48 h exposure time. Comparable with ampicillin and/or gentamycin. | [71] |
| 2.11 | COT–ZnO (Zn2+(H2O, NH4Cl, NH3)→ZnO) ZnO synthesized on the surface of COT via a simple wet chemical route. | Antibacterial tests against Sa and Kp (the presence of a significant inhibition zone of at least 1 mm around the fabric) revealed good bacteriostatic activity. However, the negligible reduction in the number of bacteria proved the lack of bactericidal activity. | [72] |
| 2.12 | COT–ZnO (1%) (Zn2+ (H2O, At)) ZnO resuspended in water (20 ppm) was coated on cotton. | The treatment of the cotton fabrics with ZnO-NPs was carried out at a safe dose (20 ppm). At this dose, ZnO-NP-loaded samples exhibited reasonable antibacterial activity against Sa, Bs, Ec, and Pa. | [73] |
| Extracts Abbreviations | Starting Materials | Exposure Medium (NC) /a | ||||
|---|---|---|---|---|---|---|
| COT | COT–Zn /b | E-COT (100%) | E-COT–Zn (100%) | Extraction /c | Dilution | |
| E-COT (100%) | 0.1 g | 1.n1 mL | ||||
| E-COT (50%) | 0.5 mL | 0.5 mL | ||||
| E-COT–Zn (100%) | 0.1 g | 1.n2 mL | ||||
| E-COT–Zn (50%) | 0.5 mL | 0.5 mL | ||||
| E-COT–Zn (25%) | 0.25 mL | 0.75 mL | ||||
| Sample | Quantitative Content of Elements (wt.%) | ||
|---|---|---|---|
| C | O | Zn | |
| COT | 40.04 | 59.96 | - |
| COT–Zn-10 (1 s) | 3.20 | 17.70 | 79.73 |
| Sample Name | Zn Concentration (g/kg) |
|---|---|
| COT | 0.01 |
| COT–Zn-5 (1 s) | 9.06 |
| COT–Zn-10 (1 s) | 20.19 |
| COT–Zn-10 (2 s) | 41.52 |
| Sample | Conc. | Zone Inhibition Diameters (mm) /a | Ref. | |||||||
|---|---|---|---|---|---|---|---|---|---|---|
| Gram-Negative | Gram-Positive | |||||||||
| Ec | Kp | Pa | Pm | Bs | Ef | Sa | Se | |||
| ZnSO4 | 2 mg/mL | 17 | 14 | 14 | 15 | 28 | 15 | [127] | ||
| ZnSO4 | 10 mg/mL | 23 | 26 | 21 | 23 | 38 | 26 | |||
| ZnO NPs | 1 mg/mL | 16 | 19 | 18 | [128] | |||||
| ZnO NPs | 1 mg/mL | 18 | 15 | [129] | ||||||
| ZnO (ZOE) | 3 | [130] | ||||||||
| ZnCl2 | 6 mg/mL | - | - | - | - | - | [131] | |||
| Zn(Li)2(W)2 | 6 mg/mL | - | - | - | 10 | 12 | ||||
| Zn(Li)2(L2)(W)2 | 6 mg/mL | 14 | 11 | 14 | 12 | 15 | ||||
| ZnO NPs | 50 μg/mL | 24 | 16 | 26 | 24 | 22 | [132] | |||
| COT /b | 0.01 mg/g | 0 | 0 | This work /c | ||||||
| COT–Zn-5 (1 s) /b | 9.0 mg/g | 1 | 0 | |||||||
| COT–Zn-10 (1 s) /b | 20 mg/g | 1 | 1 | |||||||
| COT–Zn-10 (2 s) /b | 42 mg/g | 1 | 1 | |||||||
| No | Zinc Compounds/Composites /a | Deposition /b | Fungal Average Zone Inhibition Diameters (ZID: mm) /c,d | Ref. | ||||
|---|---|---|---|---|---|---|---|---|
| An | Afl | Afu | Ca | Cg | ||||
| 1 | ZnO | 1 mg/mL | 8 | 8 | [133] | |||
| 2 | ZnO NPs | 1 mg/mL | 18 | 20 | [134] | |||
| 0.4 mg/mL | 35 | [135] | ||||||
| 50 μg/mL | 16 | 19 | [132] | |||||
| ZnO NPs | 1 μg/mL | 24 | 28 | [136] | ||||
| Zn(OAc)2 | 1 μg/mL | 20 | 21 | |||||
| ZnO NPs | 1 mg/disc | 6 | 8 | 6 | [137] | |||
| 10 mg/disc | 8 | 11 | 8 | |||||
| 0.02 mg/mL | 10 | 5 | 7 | 14 | [138] | |||
| 0.1 mg/mL | 13 | 10 | 11 | 19 | ||||
| /e | 0–9 /e,f | 0–8 /e | [139] | |||||
| 3 | ZnO/CuO (1:1) NPs | 0.5 mg/mL | 0 | 0 | [140] | |||
| 4 | hAp | 5μg | 12 | 13 | [141] | |||
| hAp–Zn (15%) | 5μg | 12 | 18 | |||||
| 5 | Cell/Cts/ZnO | 0.25% | 9–11 | [142] | ||||
| 6 | CTS–ZnO film | 1 mg/mL | 14 | 4 | [143] | |||
| 7 | PS/ZnO-NPs (5%) | 19 | 20 | [144] | ||||
| 8 | ZnO NPs–eugenol | 26 μg/L | 24 | [145] | ||||
| 9 | PLA–ALG–Zn2+ | 1.2% | 1 | 1 | [146] | |||
| PLA–ALG–Zn2+ | 4.0% | 1 | 1 | |||||
| 10 | COT–ZnO | /f | 10 | [147] | ||||
| COT–ZnO–MnO2(1:1) | /f | 12 | ||||||
| 11 | COT /b | 0.01 mg/g | 0 /g,h | 0 /g,h | This work | |||
| COT–Zn-5 (1 s) /b | 9.0 mg/g | 0 /g,h | 0 /g,h | |||||
| COT–Zn-10 (1 s) /b | 20 mg/g | 1 /g,h | 1 /g,h | |||||
| COT–Zn-10 (2 s) /b | 42 mg/g | 1 /g,h | 1 /g,h | |||||
Publisher’s Note: MDPI stays neutral with regard to jurisdictional claims in published maps and institutional affiliations. |
© 2022 by the authors. Licensee MDPI, Basel, Switzerland. This article is an open access article distributed under the terms and conditions of the Creative Commons Attribution (CC BY) license (https://creativecommons.org/licenses/by/4.0/).
Share and Cite
Kudzin, M.H.; Giełdowska, M.; Król, P.; Sobańska, Z. Preparation of Cotton–Zinc Composites by Magnetron Sputtering Metallization and Evaluation of their Antimicrobial Properties and Cytotoxicity. Materials 2022, 15, 2746. https://doi.org/10.3390/ma15082746
Kudzin MH, Giełdowska M, Król P, Sobańska Z. Preparation of Cotton–Zinc Composites by Magnetron Sputtering Metallization and Evaluation of their Antimicrobial Properties and Cytotoxicity. Materials. 2022; 15(8):2746. https://doi.org/10.3390/ma15082746
Chicago/Turabian StyleKudzin, Marcin Henryk, Małgorzata Giełdowska, Paulina Król, and Zuzanna Sobańska. 2022. "Preparation of Cotton–Zinc Composites by Magnetron Sputtering Metallization and Evaluation of their Antimicrobial Properties and Cytotoxicity" Materials 15, no. 8: 2746. https://doi.org/10.3390/ma15082746
APA StyleKudzin, M. H., Giełdowska, M., Król, P., & Sobańska, Z. (2022). Preparation of Cotton–Zinc Composites by Magnetron Sputtering Metallization and Evaluation of their Antimicrobial Properties and Cytotoxicity. Materials, 15(8), 2746. https://doi.org/10.3390/ma15082746

